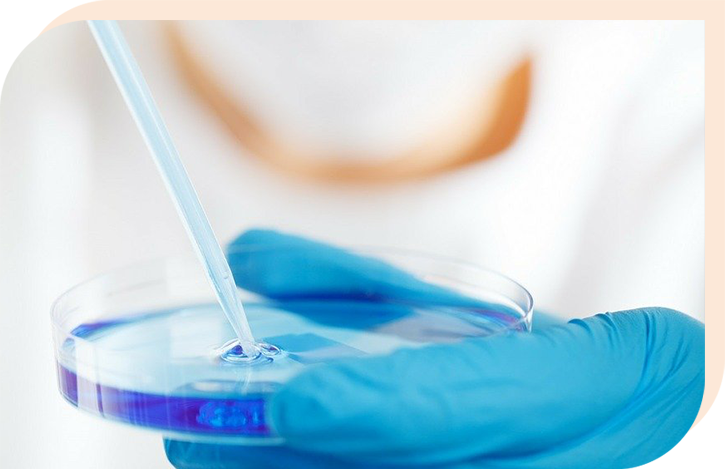

-

飲用
-

烹調
無論是飲用或是烹調皆可使用
讓純水淨化身體;使食材變得更鮮甜。

本工廠投保富邦產物1,000萬產品責任險

PURE WATER


宜興快訊

Automatic Mechanization
秉持5S精神有效經營管理與健全設備-

取之宜蘭在地水源
-

透明化的製造流程
-

經濟部合格認證











